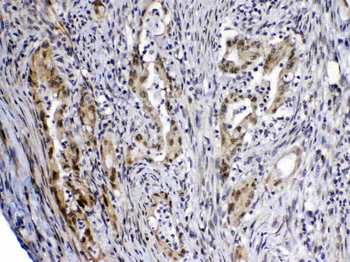
MED4 Antibody

You have no items in your shopping cart.
Description
Research Area
Images & Validation
−
Key Properties
−| CAS Number | 137339-65-2 |
|---|---|
| MW | 1739.94 Da |
| Purity | > 95% by hplc |
| Formula | C81H118N20O23 |
| Protein Sequence | H-Ser-Phe-Leu-Leu-Arg-Asn-Pro-Asn-Asp-Lys-Tyr-Glu-Pro-Phe-OH |
Storage & Handling
−| Storage | Store dry, frozen and in the dark |
|---|---|
| Form/Appearance | Freeze dried solid |
| Expiration Date | 12 months from date of receipt. |
| Disclaimer | For research use only |
Alternative Names
−Similar Products
−ACP5 Rabbit Polyclonal Antibody [orb2250]
FC, WB
Canine, Equine, Porcine, Rabbit, Rat
Human, Mouse
Rabbit
Polyclonal
Unconjugated
100 μl, 200 μl, 50 μlTRAP alpha/TRAPA/SSR1 Rabbit Polyclonal Antibody [orb763084]
ELISA, FC, ICC, IF, IHC, IP, WB
Human, Monkey, Mouse, Rat
Rabbit
Polyclonal
Unconjugated
100 μgHuman CD40LG protein [orb705340]
Greater than 87% as determined by SDS-PAGE.
44.5 kDa
Mammalian cell
1 mg, 20 μg, 100 μgMED4 Rabbit Polyclonal Antibody [orb402569]
ELISA, IHC, WB
Human, Mouse, Rat
Rabbit
Polyclonal
Unconjugated
100 μg

Quality Guarantee
Explore bioreagents carefree to elevate your research. All our products are rigorously tested for performance. If a product does not perform as described on its datasheet, our scientific support team will provide expert troubleshooting, a prompt replacement, or a refund. For full details, please see our Terms & Conditions and Buying Guide. Contact us at support@biorbyt.com.
Documents Download
Request a Document
Protocol Information
TRAP (orb1147027)
Participating in our Biorbyt product reviews program enables you to support fellow scientists by sharing your firsthand experience with our products.
Login to Submit a Review